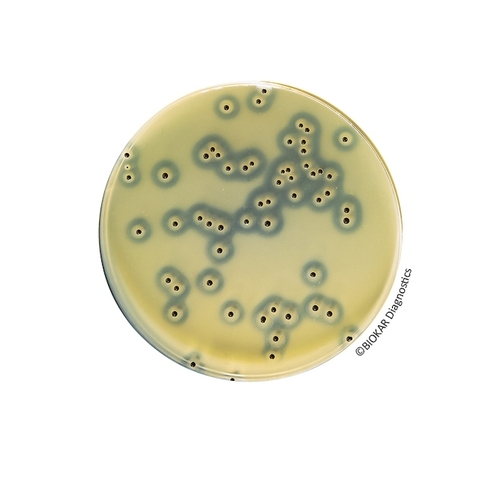
Baird-Parker Agar With Egg Yolk Tellurite

| Ürün Adı |
Sulfamethazine 25 mg Selective Supplement |
| Ürün Kodu |
BS02808 |
| Miktar |
10 vials qsp 500 mL |
| Ürün Adı |
Sterile Egg Yolk Tellurite Enrichment |
| Ürün Kodu |
BS06008 |
| Miktar |
10 vials of 50 mL |
| Ürün Adı |
Sterile Egg Yolk Tellurite Enrichment |
| Ürün Kodu |
BS03608 |
| Miktar |
1 vial of 900 mL |
| Ürün Adı |
Baird-Parker Agar With Egg Yolk Tellurite (without egg yolk or tellurite) |
| Ürün Kodu |
BK055HA |
| Miktar |
500 g |
| Ürün Adı |
Baird-Parker Agar With Egg Yolk Tellurite (without egg yolk or tellurite) |
| Ürün Kodu |
BK055GC |
| Miktar |
5 kg |
| Ürün Adı |
Baird-Parker Agar With Egg Yolk Tellurite |
| Ürün Kodu |
BM09108 |
| Miktar |
120 Petri plates Ø 90 mm |
| Ürün Adı |
Baird-Parker Agar With Egg Yolk Tellurite |
| Ürün Kodu |
BM01808 |
| Miktar |
20 Petri plates Ø 90 mm |